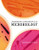

Product Overview
Key Benefit: Containing 57 thoroughly class-tested exercises, this manual provides basic microbiology techniques with applications for undergraduatereaders in diverse areas, including the biological sciences, the allied health sciences, agriculture, environmental science, nutrition, pharmacy, and various pre-professional programs. The Ninth Edition features a new, four-color design and a dramatically new art program. Many of the illustrations have been re-rendered in a modern, realistic, three-dimensional style, and detailed, colorful photomicrographs that were once grouped together in a color insert are now integrated throughout the exercises. Experiments have been refined throughout, and a new exercise on parasitic helminths readers with valuable practice in microscopic examination and observation.
Key Topics: Use and Care of the Microscope, Examination of Living Microorganisms, Microbes in the Environment, Transfer of Bacteria: Aseptic Techniques, Preparation of Smears and Simple Staining, Negative Staining, Gram Staining, Acid-fast Staining,
Structural Stains (Endospore, Capsule, Flagella), Morphologic Unknown, Isolation of Bacteria by Dilution Technique, Special Media for Isolating Bacteria, Carbohydrate Catabolism, Fermentation, Protein Catabolism, Part 1, Protein Catabolism, Part 2, Respiration,
Unknown Identification and Bergeys Manual, Oxygen and the Growth of Bacteria, Determination of a Bacterial Growth Curve: The Role of Temperature, Biofilms,Physical Methods of Control: Heat, Physical Methods of Control: Ultraviolet Radiation, Chemical Methods of Control: Disinfectants and Antiseptics, Chemical Methods of Control: Antimicrobial Drugs, Effectiveness of Hand Scrubbing, Regulation of Gene Expression, Isolation of Bacterial Mutants, Transformation of Bacteria, DNA Fingerprinting,
Genetic Engineering, Ames Test for Detecting Possible Chemical Carcinogens, Fungi: Yeasts and Molds, Phototrophs: Algae and Cyanobacteria 35. Protozoa, Parasitic Helminths, Isolation and Titration of Bacteriophages, Plant Viruses, Epidemiology, Kochs Postulate, Nonspecific Resistance, Blood Group Determination: Slide Agglutination, Agglutination Reactions: Microtiter Agglutination, ELISA Technique, Bacteria of the Skin, Bacteria of the Respiratory Tract,Bacteria of the Mouth, Bacteria of the Gastrointestinal Tract, Bacteria of the Genitourinary Tract, Rapid Identification Methods, Identification of an Unknown from a Clinical Sample, Microbes in Water: Multiple-Tube Technique, Microbes in Water: Membrane Filter Technique,
Microbes in Food: Contamination, Microbes Used in the Production of Foods, Microbes in Soil: The Nitrogen and Sulfur Cycles,
Microbes in Soil: Bioremediaton
Market: Intended for those interested in learning the basics of microbiology